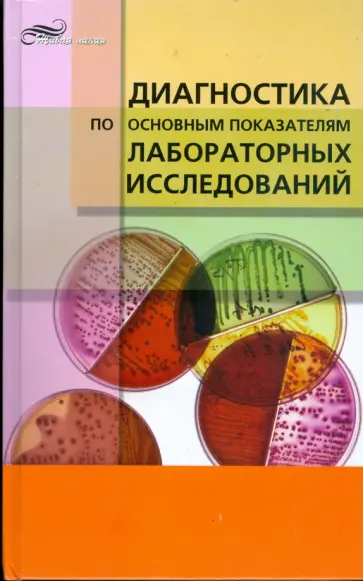
Валентин Земцов - Диагностика по основным показателям лабораторных исследований обложка книги

Издательство «Феникс»
Серия «Живая линия»
Издательство Феникс — одно из старейших в России. 35 лет успешной работы на книжном рынке. Сейчас «Феникс» — это свыше 7500 наименований книг и более 1000 книжных новинок, выпускаемых ежегодно. Книги охватывают широкий тематический диапазон. Это художественная литература, учебники и учебные пособия для вузов и колледжей; нон-фикшн: книги по психологии, юриспруденции и экономике, социальным и естественным наукам; техническая литература; детская и педагогическая литература; учебники по шахматам и многое другое.
Издательство «Феникс» выпускает книги авторов, которые хорошо знакомы множеству читателей: Ник Перумов, Михаил Литвак, Вячеслав Оробинский, Татьяна Соломатина, Андрей Белянин, Валентина Паевская, Елена Ульева, Жанна Андриевская, Владимир Сурдин, Елена Молчанова, Ольга Бочкова, Говард Лавкрафт и многие другие.
Более 215 000 000 экземпляров книг было выпущено за годы работы издательства «Феникс». Популярные серии «Хроники Некрономикона», «Психологический практикум», «Просто о сложном», «Удивительная Русь» и многие другие завоевали доверие читателей разных стран и возрастов.
Литература издательства «Феникс» пользуется стабильным спросом у читателей, и с каждым годом число наших покупателей по всей России и за рубежом увеличивается. Качество продукции неизменно поддерживается на высоком уровне. «Феникс» всегда следит за трендами, анализируя состояние книжного рынка и расширяя направления своей деятельности.
Если Вы обнаружили ошибку на странице серии "Живая линия", пишите об этом в сообщении об ошибке. Спасибо!
Не знаете, что почитать?